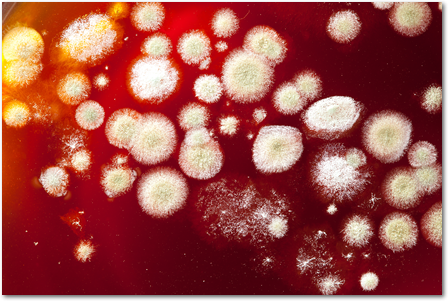

What would happen if organisms of a certain species were not able to reproduce? That species would not be able to exist for more than one generation. Reproduction allows species to exist from one generation to the next by passing on genetic information.
All organisms must reproduce, but not all organisms reproduce the same way. Some organisms reproduce through asexual reproduction. Asexual reproduction is when one organism produces offspring that are identical to itself. There is only one parent in asexual reproduction, so an offspring receives all of its genes from one parent. Some advantages of asexual reproduction are it is efficient and often reproduction is quick. Disadvantages include no variation and no adaptability over generations.
Mold can reproduce asexually through the use of spores.